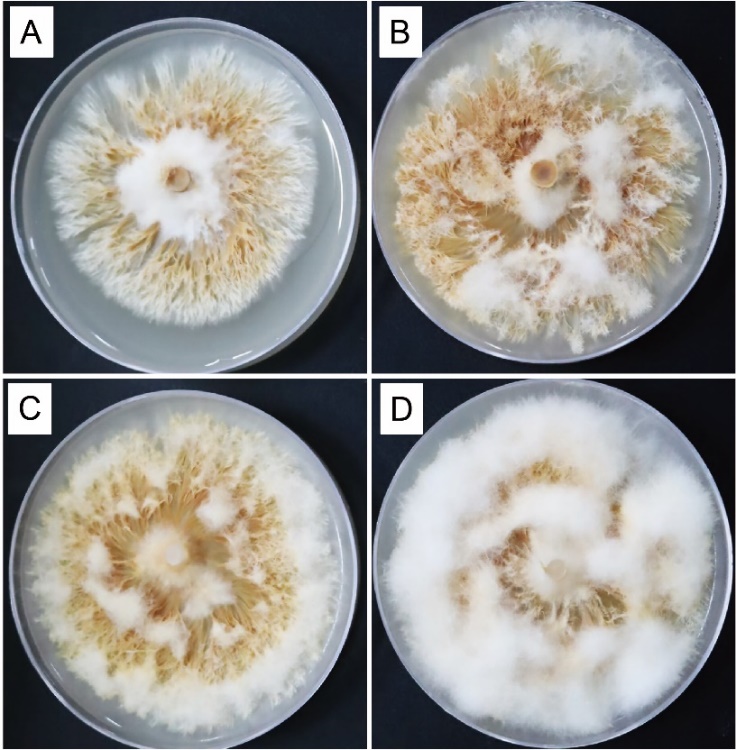

马尾松(Pinus massoniana)是我国特有的速生、丰产乡土树种,是松属树种地理分布最广的一种,广泛分布于我国亚热带东部湿润区,并延至北热带;其自然连续分布面积大约220万km2。马尾松是贫瘠山地生态恢复过程中的重要树种,也是我国山区及丘陵地区绿化造林的重要树种;以广西壮族自治区为例,马尾松人工林面积高达178万公顷。外生菌根(ectomycorrhizas,ECM)是由外生菌根真菌菌丝体侵染宿主植物尚未木栓化的营养根形成的,其主要特征是真菌菌丝体不进入细胞内部,而仅在根系表面和细胞壁之间延伸生长,形成一个紧密交织的菌套,并在根的皮层细胞间形成类似网状结构的“哈氏网”。统计数据表明,全球范围内约有90个属、5000~6000种真菌可与树木形成外生菌根。马尾松是外生菌根真菌重要的共生树种。外生菌根对提高马尾松对重金属、干旱等胁迫的适应能力以及增强营养元素的吸收等方面具有重要的功能,在保持马尾松人工林森林生态系统稳定与平衡以及物质和能量循环等方面发挥了巨大的作用。此外,其中的可食用外生菌根菌还能提供营养丰富、经济价值非常高的珍稀菌根食用菌子实体(例如松乳菇、牛肝菌、鸡油菌、松露等)。因此,筛选收集广西壮族自治区本土可食用外生菌根菌资源,解析外生菌根真菌与马尾松形成菌根的形态特征以及共生分子机制,不仅具有重要的科学价值,也是发展马尾松人工林林下经济的前提。然而,目前尚未有针对广西壮族自治区内马尾松人工林外生菌根菌资源收集与菌根合成等方面的研究报道。
本研究对从马尾松人工林采集筛选的一株红汁乳菇菌株Lactarius hatsudake GX01的最适固体培养基、培养基最适pH值以及不同固体培养基培养条件下的菌落形态进行分析;以固体培养基培养的L. hatsudake GX01为菌剂接种侵染无菌速生马尾松幼苗,通过体视显微镜和扫描电子显微镜观察,证实侵染1个月后即可成功合成红汁乳菇-马尾松菌根苗;进一步分析发现L. hatsudake GX01侵染马尾松形成菌根的过程中能显著增加侧根的数量;形成的珊瑚状菌根的不同部位的菌套厚度不一样。本研究成功建立的马尾松-红汁乳菇菌根合成技术,对于后续进一步深入研究马尾松-红汁乳菇的共生分子机制以及后续的应用推广奠定了基础。
相关的研究以“Establishment of Pinus massoniana–Lactarius hatsudake symbiosis”为题发表于农林科学类学术期刊《Forests》(中科院二区,最新IF=2.90)。论文第一单位为广西师范大学珍稀濒危动植物生态与环境保护教育部重点实验室,2021级硕士研究生魏智能为论文第一作者,刘霖老师为论文共同第一作者,2023级硕士研究生雷乙丹,2021级本科生谢思思为共同作者;我院马姜明教授,广西壮族自治区植物研究所唐年武副研究员,以及广西壮族自治区林业科学研究院谭一波研究员共同参与了本论文相关研究;广西师范大学艾郴兵副教授与广西壮族自治区林业科学研究院杨章旗教授级高级工程师为共同通讯作者。本研究同时得到了广西重点研发计划项目(AB22080072, AB21220057)、广西科技计划项目(AD21220074)、广西漓江流域景观资源保育与可持续利用重点实验室主任基金(LRCSU21Z0316)、桂林兴安漓江源森林生态系统广西野外科学观测研究站科研能力建设项目(GXSTP 22-035-130-02)以及桂林兴安漓江源森林生态系统广西野外科学观测研究站开放课题(LJF-2022KF01)等的资助。
全文链接:https://doi.org/10.3390/f15040578.

图1. 红汁乳菇菌株L. hatsudake GX01子实体.
图2. 不同pH值PDA培养基培养的红汁乳菇L. hatsudake GX01菌落形态差异(A, pH 4.0; B, pH 5.0; C, pH 6.0; D, pH 7.0).

图3. 非菌根马尾松与菌根化马尾松根部形态差异(A-C, 非菌根马尾松的根; D-F, 菌根化马尾松的根).

图4. 非菌根马尾松与菌根化马尾松根部横切面形态差异(A、B, 非菌根马尾松的根; C-D, 菌根化马尾松的根).
桂公网安备45030502000260号)